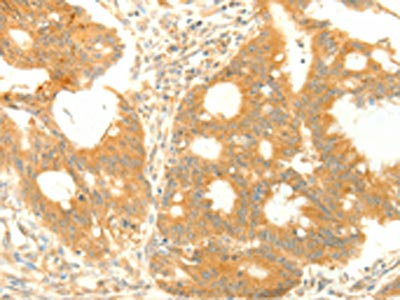

TRAF3IP2 Antibody
-
中文名稱:TRAF3IP2兔多克隆抗體
-
貨號:CSB-PA025221
-
規格:¥1100
-
圖片:
-
The image on the left is immunohistochemistry of paraffin-embedded Human colon cancer tissue using CSB-PA025221(TRAF3IP2 Antibody) at dilution 1/25, on the right is treated with fusion protein. (Original magnification: ×200)
-
The image on the left is immunohistochemistry of paraffin-embedded Human liver cancer tissue using CSB-PA025221(TRAF3IP2 Antibody) at dilution 1/25, on the right is treated with fusion protein. (Original magnification: ×200)
-
Gel: 10%SDS-PAGE, Lysate: 40 μg, Lane: Jurkat cells, Primary antibody: CSB-PA025221(TRAF3IP2 Antibody) at dilution 1/400, Secondary antibody: Goat anti rabbit IgG at 1/8000 dilution, Exposure time: 20 seconds
-
-
其他:
產品詳情
-
Uniprot No.:
-
基因名:
-
別名:Act 1 antibody; ACT1 antibody; Activator of cAMP responsive element modulator (CREM) in testis antibody; Adapter protein CIKS antibody; C6ORF4 antibody; C6ORF5 antibody; C6ORF6 antibody; Chromosome 6 Open Reading Frame 4 antibody; Chromosome 6 Open Reading Frame 5 antibody; Chromosome 6 Open Reading Frame 6 antibody; CIKS_HUMAN antibody; Connection to IKK and SAPK / JNK antibody; Connection to IKK and SAPK/JNK antibody; Nuclear Factor Kappa B Activator 1 antibody; Nuclear factor NF kappa B activator 1 antibody; Nuclear factor NF-kappa-B activator 1 antibody; TRAF3 interacting protein 2 antibody; TRAF3-interacting protein 2 antibody; TRAF31P2 antibody; TRAF3IP2 antibody
-
宿主:Rabbit
-
反應種屬:Human
-
免疫原:Fusion protein of Human TRAF3IP2
-
免疫原種屬:Homo sapiens (Human)
-
標記方式:Non-conjugated
-
抗體亞型:IgG
-
純化方式:Antigen affinity purification
-
濃度:It differs from different batches. Please contact us to confirm it.
-
保存緩沖液:-20°C, pH7.4 PBS, 0.05% NaN3, 40% Glycerol
-
產品提供形式:Liquid
-
應用范圍:ELISA,WB,IHC
-
推薦稀釋比:
Application Recommended Dilution ELISA 1:1000-1:2000 WB 1:200-1:1000 IHC 1:25-1:100 -
Protocols:
-
儲存條件:Upon receipt, store at -20°C or -80°C. Avoid repeated freeze.
-
貨期:Basically, we can dispatch the products out in 1-3 working days after receiving your orders. Delivery time maybe differs from different purchasing way or location, please kindly consult your local distributors for specific delivery time.
-
用途:For Research Use Only. Not for use in diagnostic or therapeutic procedures.
相關產品
靶點詳情
-
功能:E3 ubiquitin ligase that catalyzes 'Lys-63'-linked polyubiquitination of target protein, enhancing protein-protein interaction and cell signaling. Transfers ubiquitin from E2 ubiquitin-conjugating enzyme UBE2V1-UBE2N to substrate protein. Essential adapter molecule in IL17A-mediated signaling. Upon IL17A stimulation, interacts with IL17RA and IL17RC receptor chains through SEFIR domains and catalyzes 'Lys-63'-linked polyubiquitination of TRAF6, leading to TRAF6-mediated activation of NF-kappa-B and MAPkinase pathways.
-
基因功能參考文獻:
- AP1 binding sites were enriched upstream of genes up-regulated by TRAF3IP2 silencing. Correspondingly, nuclear expression of FosB and Fra1 was increased in TRAF3IP2-silenced cells. Many genes involved in host defense were induced by IL-17 in a TRAF3IP2-dependent fashion. PMID: 28274739
- TRAF3IP2 SNP rs33980500 associated with no achievement of low disease activity nor remission at 6 months PMID: 28107378
- the first report to describe a non-adaptor function of Act1 by directly binding to the promoter region of IL-17A responsive genes and directly regulate their transcription. PMID: 27723765
- ACT1 is an essential adaptor molecule of Il-17-induced expression of inflammation-related gene targets. PMID: 27660002
- Both the ACT-1 assay and the MAdCAM-1 assay demonstrated acceptable reproducibility and repeatability. The assays were sufficiently stable to allow for clinical use. During clinical testing the assays demonstrated that vedolizumab was able to saturate peripheral cells at all doses tested. PMID: 25908521
- A G/G genotype of rs766748 in IL-17F, and a C/C or C/A genotype of rs1883136 in TRAF3IP2. PMID: 26558270
- The suppressive effects of miR-30a were mediated by directly targeting Traf3ip2 mRNA PMID: 26376209
- TRAF3IP2 may play a causal role in aldosterone-induced adverse cardiac remodeling in vivo. PMID: 26148936
- Single nucleotide polymorphisms in RBPJ, IL1R1, REV3L, TRAF3IP2, IRF1 and ICOS showed association with rheumatoid arthritis in black South Africans. PMID: 25014791
- A variant (rs76228616 SNP) in TRAF3IP2 gene could be involved in susceptibility to Steven-Johnson Syndrome. PMID: 25775161
- identify Syk as an upstream signaling molecule in IL-17A-induced Act1-TRAF6 interaction in keratinocytes, and inhibition of Syk can attenuate CCL20 production PMID: 25202827
- These results indicate that oxLDL-induced endothelial cell death and dysfunction are mediated via TRAF3IP2 and that native HDL3 and the AMPK activators inhibit this response. PMID: 24561578
- Replicate the association of TRAF3IP2-_rs33980500 variant with the susceptibility to psoriasis. PMID: 24005976
- this study demonstrated that although ACT1-v2-D10N is nonfunctional, ACT1-v1-D19N retains the ability to interact with Hsp90 and is fully responsive to IL-17A stimulation. PMID: 25024377
- Genetic polymorphism in the TRAF3IP2 gene is associated with psoriasis vulgaris in a Japanese population. PMID: 24373565
- This study provides evidence that TRAF5 and TRAF3IP2 genes are involved in the development ofBehcet's disease (BD) and Vogt-Koyanagi-Harada (VKH) syndrome. PMID: 24416204
- Results suggest that Act1 might play a key role in the pathophysiology and the treatment of rheumatoid arthritis. PMID: 23862741
- Human IL-17A and IL-17F depend on ACT1 to mediate protective mucocutaneous immunity. PMID: 24120361
- Data show the contribution of TRAF3IP2 genetic variability in Systemic lupus erythematosus (SLE) susceptibility. PMID: 23836313
- Deletion of Act1 in NG2-positive glia results in markedly reduced experimental autoimmune encephalomyelitis in transgenic mice. PMID: 23995070
- our findings suggest that TRAF3IP2 variants contribute to cutaneous extarintestinal manifestations of both Crohn's disease and ulcerative colitis. PMID: 22445837
- In psoriatic arthritis patients the TRAF3IP2-variant p.Asp10Asn is the only susceptiblity allele with functional impact on TRAF6 binding. PMID: 22513239
- IL-17 receptor adaptor protein Act1/CIKS plays an evolutionarily conserved role in antiviral signaling. PMID: 23066157
- The findings define a new role for the IKK-related kinases in suppressing IL-17-mediated NF-kappaB activation through TRAF6-dependent Act1 phosphorylation. PMID: 22851696
- A CIKS mutant may promote the initiation of psoriatic inflammation PMID: 22581863
- Act-1 contributed to the stimulatory effect of IL-17 on RAGE production in rheumatoid arthritis PMID: 21749686
- Data indicate that knockdown of beta-TrCP1 and beta-TrCP2 markedly reduced IL-17-induced, phosphorylation-dependent ubiquitination and degradation of Act1. PMID: 22045853
- TRAF3IP2 represents a shared susceptibility for PMID: 20953188
- Act1 transgene functions as an important regulator of B cell activating factor (BAFF)-mediated survival of transitional B cells and their maturation into follicular and marginal zone B cells. PMID: 20543113
- Endogenous Act1 is recruited to the CD40 receptor in human intestinal (HT29) and cervical (HeLa) epithelial cells upon stimulation with CD40 ligand, indicating that Act1 is involved in this signaling pathway. PMID: 12089335
- Data indicate that the newly identified alternatively spliced Act1 is a major transcript of the molecule and that Act1 may play important roles in oncogenesis. PMID: 12163033
- CIKS forms homo-oligomers, interacts with NEMO/IKKgamma, and is recruited to the IKK-complex upon cell stimulation PMID: 12943667
- two independent and indispensable signaling pathways-1) JAK1-associated PI3K signaling and 2) Act1/TRAF6/TAK1-mediated NF-kappaB activation-are stimulated by IL-17A to regulate gene induction in human airway epithelial cells. PMID: 17982039
- Whereas Act1 interacts with the IL-17R through the C-terminal SEFIR domain, Act1 is recruited to CD40 and BAFFR indirectly, which is mediated by TRAF3 through the TRAF binding site in Act1[review] PMID: 18061473
- Act1 mediates IL-17-induced signaling pathways through its E3 ubiquitin ligase activity and TRAF6 is a critical substrate of Act1, which indicates the importance of protein ubiquitination in the IL-17-dependent inflammatory response PMID: 19825828
顯示更多
收起更多
-
相關疾病:Psoriasis 13 (PSORS13); Candidiasis, familial, 8 (CANDF8)
-
組織特異性:Widely expressed.
-
數據庫鏈接:
Most popular with customers
-
-
YWHAB Recombinant Monoclonal Antibody
Applications: ELISA, WB, IHC, IF, FC
Species Reactivity: Human, Mouse, Rat
-
Phospho-YAP1 (S127) Recombinant Monoclonal Antibody
Applications: ELISA, WB, IHC
Species Reactivity: Human
-
-
-
-
-